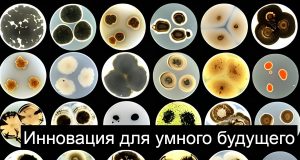
Синапс, созданный из скорлупы, бобов и растительных волокон, имитирует человеческий мозг Home
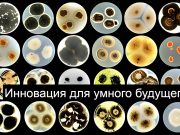
Синапс, созданный из скорлупы, бобов и растительных волокон, имитирует человеческий мозг Home

Последние новости
Генпрокуратура предупреждает о новой киберугрозе для казахстанцев
Доступ к крупным базам персональных данных будет защищён биометрией
YouTube удалил крупнейшие каналы с фейковыми трейлерами, созданными при помощи ИИ
Телевизор Xiaomi TV A Pro 2026. Для тех, кто выбирает «умную технику»!
Еженедельный дайджест самых интересных новостей и обзоров
Старт ракеты «Союз 5/Сункар» с комплекса «Байтерек» на Байконуре – все идет по плану
Инвесторы предупреждают о надувающемся пузыре вокруг человекоподобных роботов
Этот “опасный” 1414 или почему нужна постоянная бдительность
Казахстан лидирует по готовности к внедрению искусственного интеллекта среди стран Центральной Азии
Илон Маск перенес прогноз по созданию AGI с 2025 на 2026 год
Запущена республиканская программа по внедрению ИИ в систему технического и профессионального образования
В Казахстане появится Цифровой ГОСТ
Глава OpenAI назвал Google крупной угрозой и пообещал объявлять красную тревогу дважды в год
Как «цифра» город защитит
Новые двигатели могут сделать электромобили на 450 кг легче и увеличить запас хода
Мария Рахманина: «ASUS начнет формировать технологическую повестку tech-сообщества региона!»
ПОСЛЕДНИЕ ОБЗОРЫ
ПОСЛЕДНИЕ НОВОСТИ
Электроника
Еженедельный дайджест самых интересных новостей и обзоров
Технологии
Генпрокуратура предупреждает о новой киберугрозе для казахстанцев
Еженедельный дайджест самых интересных новостей и обзоров
Профессионал
Как создать новогоднее настроение с помощью ИИ?
Синапс, созданный из скорлупы, бобов и растительных волокон, имитирует человеческий мозг
Илон Маск перенес прогноз по созданию AGI с 2025 на 2026 год
Глава OpenAI назвал Google крупной угрозой и пообещал объявлять красную тревогу дважды в год
Как «цифра» город защитит
Мария Рахманина: «ASUS начнет формировать технологическую повестку tech-сообщества региона!»
Прочитано в соцсети. Прежде чем что-то делать или декларировать – посчитайте!
Мобильные новости и обзоры гаджетов
Добро пожаловать на портал Mobilaser! Здесь ежедневно публикуются новости мобильного мира: все об электронике, мобильных устройствах и телефонах, а также анонсы тематических событий в Казахстане. ...
Каждый день наши журналисты ищут новейшие мобильные новости и новости IT, науки и техники, чтобы вы первыми узнали о них. Подбираем только самые важные и интересные поводы, а также берем интервью у авторитетных экспертов отрасли! Потому что создать нескучный сайт о гаджетах означает не только публиковать полезные новости мобильной электроники, но и объективно обозревать смартфоны, компьютеры, наушники, технику, технологии, приложения, мобильные аксессуары и многое другое.
Сегодня электронная промышленность дает нам много инфоповодов, чтобы регулярно генерировать новости мобильных телефонов, всевозможной техники, которая еще вчера казалась фантастической, а сегодня уже стала частью нашей повседневной жизни. Технический прогресс настолько стремительный, что мы узнаем о новых технологиях буквально каждый день. Поэтому будьте в курсе актуальных новостей мобильного мира вместе с Mobilaser!